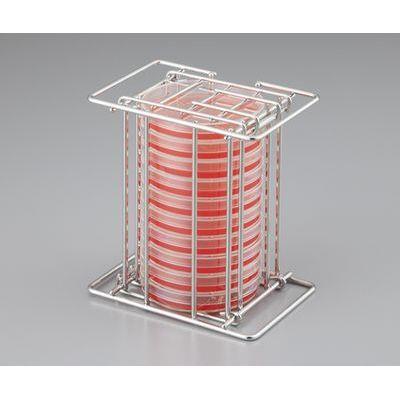

逆さ置き対応シャーレラック - 2-4217-01
メーカー:アズワン
●シャーレ収納後まとめて上下を逆さにし、インキュベータに入れることができるので効率よく菌検査ができます。
●開閉可能なフタが上下に付いているので、どちらからでもシャーレが取り出せます。
【仕様】
●材質:ステンレス(SUS304)
●シャーレ収納数:10枚(シャーレ高さ:15mmの場合)
●適応シャーレ径:φ90mm
詳細情報・スペック
| 商品コード | 00512183 |
|---|---|
| 型式 | 2-4217-01 |
| 販売価格 |
9,215円(税抜) 10,136円(税込) |
| 在庫/出荷目安 |
|
|---|
逆さ置き対応シャーレラック - 2-4217-01のレビュー
逆さ置き対応シャーレラック[アズワン]の商品詳細です。逆さ置き対応シャーレラックのレビューやQ&Aも掲載しています。アズワンの逆さ置き対応シャーレラックをはじめとする継手・フランジをお得な値段で購入できる配管部品.comはプロ向け配管部品の通販サイトです。
ご購入ガイド
配送について
送料は全国一律770円(税込 重量10kgまで)
1回のご購入合計金額(税込)が【5,500円以上】の場合は送料無料です。
※沖縄、離島地域への送料は別途見積もりとさせていただきます。(送料無料適用対象外)
※「特別送料」の表示がある商品につきましては購入金額に関わらず別途送料がかかります。
※一部商品(重量物や長尺物など)や、一部遠隔地へのお届けには、別途送料がかかる場合があります。
※お届け日や配達時間のご指定は出来ません。
お手数ですが、お客様には以下の内容をよくお確かめの上、ご注文いただけますようお願い申し上げます。
<お届け地域>
現在は、配送便の都合上、沖縄県および離島、一部の山間奥地には商品をお届けできません。お届け先に上記地域をご指定のご注文につきましては、申し訳ございませんが、キャンセル扱いとさせていただきます(メールにてお知らせします)。
<送料>
・この商品は、通常のご購入金額による送料無料サービスは適用されません。・送料は、ご注文品の総重量を基準に、お届け地域ごとの料金がかかります。
★商品1本当たりの単体重量は商品サイズ表に記載しております。

★総重量区分(25kgごと)及びお届け地域ごとの送料は、下記送料表をご参照ください。
■塩ビパイプ商品送料表(〜100kg未満)2020年7月1日〜
| 地域 | 都道府県・地域名 | 送料(ご注文品の総重量による区分) | ||||
| 〜25kg未満 | 25〜50kg未満 | 50〜75kg未満 | 75〜100kg未満 | 100kg以上 | ||
| 北海道・東北 | 北海道、青森、岩手・秋田、 宮城、山形、福島 |
特別送料3,300円+1,100円 | 特別送料3,300円+5,500円 | 特別送料3,300円+9,900円 | 特別送料3,300円+14,300円 | 別途見積 |
| 関東 | 茨城、栃木、群馬、埼玉、 千葉、東京、神奈川、山梨 |
特別送料3,300円のみ | 特別送料3,300円+1,100円 | 特別送料3,300円+3,300円 | 特別送料3,300円+5,500円 | 別途見積 |
| 関西 | 滋賀、京都、大阪、兵庫、 奈良、和歌山 |
|||||
| その他 | 信越、東海、北陸、中国、 四国、九州 |
特別送料3,300円のみ | 特別送料3,300円+3,300円 | 特別送料3,300円+6,600円 | 特別送料3,300円+9,900円 | 別途見積 |
<ご注文の流れ>
- 1、ご注文(商品、本数、お届け先が確定)
- 2、【注文内容のご確認】メールの送信 (自動送信)
ここでは商品・数量・価格を記載しています。送料はのちに別のメールでお知らせします。 - 3、【送料のお知らせ】メールの送信(受注担当者より個別にお送りします)
上記料金表に従って追加で送料をいただきます。それ以外に送料がかかってくる場合や別途見積もりが必要な場合にのみ、個別のご連絡をさせていただきます。
※こちら当社在庫品です。本メールを送信後、順次、発送の手配をさせていただきます。
キャンセルの場合は、お手数ですが、早急にご連絡いただけますようお願い申し上げます。
- 4、商品の手配、発送準備
- 5、商品の出荷(出荷後のキャンセル・返品はお受けできません。)
- 6、送り状番号のご連絡メールの送信
<商品の引き渡し>
宅配便による配送のため、原則として「車上渡し」となりますので、アパート・マンション・個人宅へのお届けができない場合があります。出荷までの日数について
■出荷までの日数について
当サイト掲載商品にはすべて、出荷までの日数の目安を表示しています。
※商品ページに「3営業日出荷」「5営業日出荷」「10営業日出荷」「出荷日別途案内」の表記がある商品はいずれも取り寄せ商品です。出荷まで所定のお日にちを頂戴します。
16時までのご注文で当日出荷可能な商品(休業日除く)※当店の在庫がご注文数に満たない場合等により、当日発送を出来かねる場合が御座います。
ご注文日より3営業日以内に出荷可能な商品(休業日除く)
ご注文日より5営業日以内に出荷可能な商品(休業日除く)
ご注文日より10営業日以内に出荷可能な商品(休業日除く)
別途、出荷日をご連絡する商品
メーカー直送商品(FAXでのご注文はお受けできません)
別途、出荷日をご連絡する商品(在庫品欠品時の次回入荷予約)
休業日とは、土日祝日および夏季休業、年末年始ほかを示します。
詳しくは営業日カレンダーをご覧ください。
複数店舗で在庫を共有しているため、「在庫品」表示であってもご注文数によって数営業日かかる商品がございます。
■納期の異なる商品を同時にご購入頂いた際の出荷日
原則としてすべての商品の出荷準備がととのってから、まとめて出荷させていただきます。
例.「在庫品」と「5営業日内出荷」を同時にご注文頂いた場合、
5営業日内の商品の出荷準備が整い次第、同梱出荷を致します。
ただし、例外的に「予約注文」は出荷準備が整ったものから順次出荷となります。
■出荷準備が整ったものから順次出荷をご希望の場合
カート内にあります「分納配送」をご選択下さい。
詳しくはご利用ガイドの複数商品の出荷をご覧下さい。
返品・交換・キャンセルについて
当サイトでは、お客様と当社の双方に負担となる返品をなるべく減らしたいと考えています。
特にその原因となる「ミス」を防止するため受注〜出荷のあらゆるプロセスで問題点の改善に
取り組んでいます。お客様にもぜひ趣旨をご理解のうえ、ご協力いただけますようお願いします。
詳しくはご利用ガイドの返品・交換・キャンセルについてをご覧下さい。
※返品にかかる送料は、返品理由がお客様都合の場合は、お客様のご負担でお願いします。
※ご注文受付完了後の追加・変更・キャンセルはお受けできません。
お支払い方法について
お支払い方法は、クレジットカード払い・代金引換・コンビニ払い・請求書払いからお選びいただきます。
■クレジットカード
VISA、Master、JCBの各種カードがご利用いただけます。
![]()
■代金引換
配送時に運送業者が持参する領収書に記載されている総額を「現金」でお支払いください。
ご購入金額合計に応じて、代引手数料は変わります。
11,000円以下:440円 33,000円以下:550円 33,000円を超える:660円
■コンビニ払い(法人・個人事業主様 専用 )
商品到着後、コンビニ・銀行・郵便局でお支払い頂けます。
累計残高で30万円迄(他店でのネットプロテクションズご利用状況により異なります)
※請求書は株式会社ネットプロテクションズより発行されます。
※振込用紙は商品とは別で、商品到着5日〜10日後に郵送で届きます。
※与信審査にはお時間がかかります。納期には余裕を持ってご注文ください。

■請求書払い
末締め、20日締めからお選び頂けます。(締日と締日の間の1か月間に購入可能な金額3万円です。)
※請求書払いをご希望の場合は、事前に別途申請が必要です。
楽天ポイントについて
■楽天ポイントの紹介
楽天ポイントとは、楽天市場をはじめとした様々な楽天内のサービスや、楽天ペイや楽天ポイントカードの
加盟店等で貯まる!使える!便利なポイントサービスです。
■ポイント付与の注意点
商品をご購入いただく時点で楽天IDが連携済みになっていることがポイント付与の条件となります。
必ず購入前に楽天IDの連携をおこなってください。






鋼管(鉄管)・継手・フランジ・バルブ
銅管・継手・バルブ
樹脂管・継手・バルブ
ステンレス管・継手・フランジ・バルブ
エアーコンプレッサー
エアーフィルター・ドライヤー
エアーチューブ・ホース・継手
FRL・圧力計・バルブ・シリンダ
空圧機器・配管
スイッチ・サイレンサー
真空用機器・ショックアブソーバ
油圧ホース・ホースアダプター
高圧継手・フランジ・バルブ・カップリング
ロータリージョイント・スィーベルジョイント
メカトロ部品
スプレー・オイル・グリース
油さし・グリースポンプ
集中潤滑装置・給油器・継手
くい込み式継手
高真空用継手・フランジ・バルブ
テフロンチューブ・継手・バルブ
理化学配管・その他
サニタリーパイプ・継手・バルブ
一般工業用ホース
サクション・デリバリーホース
ホース継手・ホースバンド
切削工具
空調機器
環境改善機器